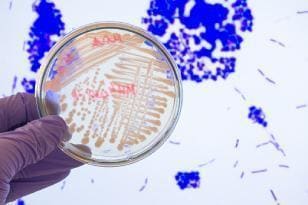

Oferta

Laboratorium diagnostyczne Dia-Bakter w Białymstoku
W laboratorium diagnostycznym Dia-Bakter w Białymstoku wykonasz zarówno podstawowe, jak i specjalistyczne badania. W naszej placówce zadbasz o swoje zdrowie kompleksowo. Morfologia krwi, badanie kału i moczu, a także specjalistyczne badania mikrobiologiczne to tylko kilka elementów spośród bogatej wersji naszych usług. Profilaktyczne badania pozwalają wykryć chorobę w jej początkowym stadium, kiedy można ją jeszcze łatwo wyleczyć lub zahamować jej rozwój. Coraz szybszy styl życia Polaków przyczynia się do wzrostu ryzyka występowania wielu chorób cywilizacyjnych – takich jak choroby układu sercowo-naczyniowego, otyłość, cukrzyca, nowotwory, choroby układu oddechowego i układu pokarmowego, osteoporoza, choroby zakaźne, alergie, choroby psychiczne i uzależnienia. Choroby cywilizacyjne XXI wieku występują już nie tylko u osób starszych, ale pojawiają się także wśród młodzieży, a nawet u dzieci. Zapoznaj się z ofertą badań laboratoryjnych i już dziś zrób pierwszy krok w stronę zdrowia!
Diagnostyka badań laboratoryjnych
Jeśli szukasz miejsca, w którym będziesz mógł dokładnie przebadać swój organizm, to dobrze trafiłeś. Stworzyliśmy miejsce przyjazne zarówno dla dzieci, jak i dorosłych, gdzie prowadzimy kompleksową diagnostykę badań. Współpracujemy również z zaufanymi laboratoriami, które specjalizują się w wykonywaniu badań biochemicznych i hematologicznych. W naszym laboratorium analizujemy próbkę na podstawie nowoczesnych technik diagnostycznych dlatego u nas masz pewność, że wynik jest w pełni wiarygodny.
Pozostałe badania, jakie wykonasz w laboratorium:
- badania alergiczne,
- badania mykologiczne, serologiczne,
- badania podstawowe i rozszerzone z krwi,
- badanie moczu,
- badanie kału,
- inne.
Nie czekaj, aż choroba da o sobie znać. Zacznij kontrolować stan własnego zdrowia robiąc podstawowe badania przynajmniej raz do roku. Centrum laboratoryjne świadczy usługi nie tylko dla pacjentów z Białegostoku. Przyjmujemy również materiał do badania z całej Polski.


Diagnostyka pasożytów
Wykonujemy badania krwi i kału na obecność pasożytów w organizmie w kierunku pierwotniaków, nicieni, tasiemców, przywr.

Oferta badań laboratoryjnych
Zapoznaj się z naszą bogatą ofertą podstawowych i specjalistycznych badań laboratoryjnych.

Panele alergiczne
Wykonujemy testy alergiczne z krwi, które pozwalają zbadać, jakie alergeny wywołują reakcję obronną organizmu.
Diagnostyka badania w Białymstoku
W naszym laboratorium w Białymstoku wykonujemy badania z zakresu diagnostyki. W codziennej pracy stawiamy na profesjonalizm i rzetelność. Wszystkie badania są przeprowadzane zgodnie z obowiązującymi standardami oraz procedurami, co gwarantuje wiarygodność wyników. Współpracujemy z lekarzami różnych specjalności, dzięki czemu jesteśmy w stanie zaoferować kompleksową diagnostykę dla szerokiego spektrum przypadłości. W zakres naszych usług wchodzą między innymi badania, alergologiczne. Jesteśmy otwarci na współpracę z placówkami medycznymi oraz innymi laboratoriami, które poszukują wsparcia w zakresie diagnostyki laboratoryjnej.
Laboratorium diagnostyczne w Białymstoku – badanie próbek z całej Polski i zza granicy
Nasz zakres działania nie ogranicza się jedynie do Białegostoku. Przyjmujemy próbki do badań laboratoryjnych z całej Polski, a nawet zza granicy. Zapewniamy szybką realizację badań oraz terminowe przekazanie wyników, zarówno w formie elektronicznej, jak i tradycyjnej. Jesteśmy otwarci na współpracę z klientami indywidualnymi oraz instytucjami z różnych regionów Polski czy zagranicy.
Nasze laboratorium diagnostyczne w Białymstoku oferuje szeroką gamę badań laboratoryjnych, zarówno dla klientów indywidualnych, jak i instytucji czy firm. Stawiamy na profesjonalizm, rzetelność oraz nowoczesne metody diagnostyczne. Przyjmujemy próbki z całej Polski oraz zza granicy, gwarantując szybką realizację badań i terminowe przekazanie wyników.